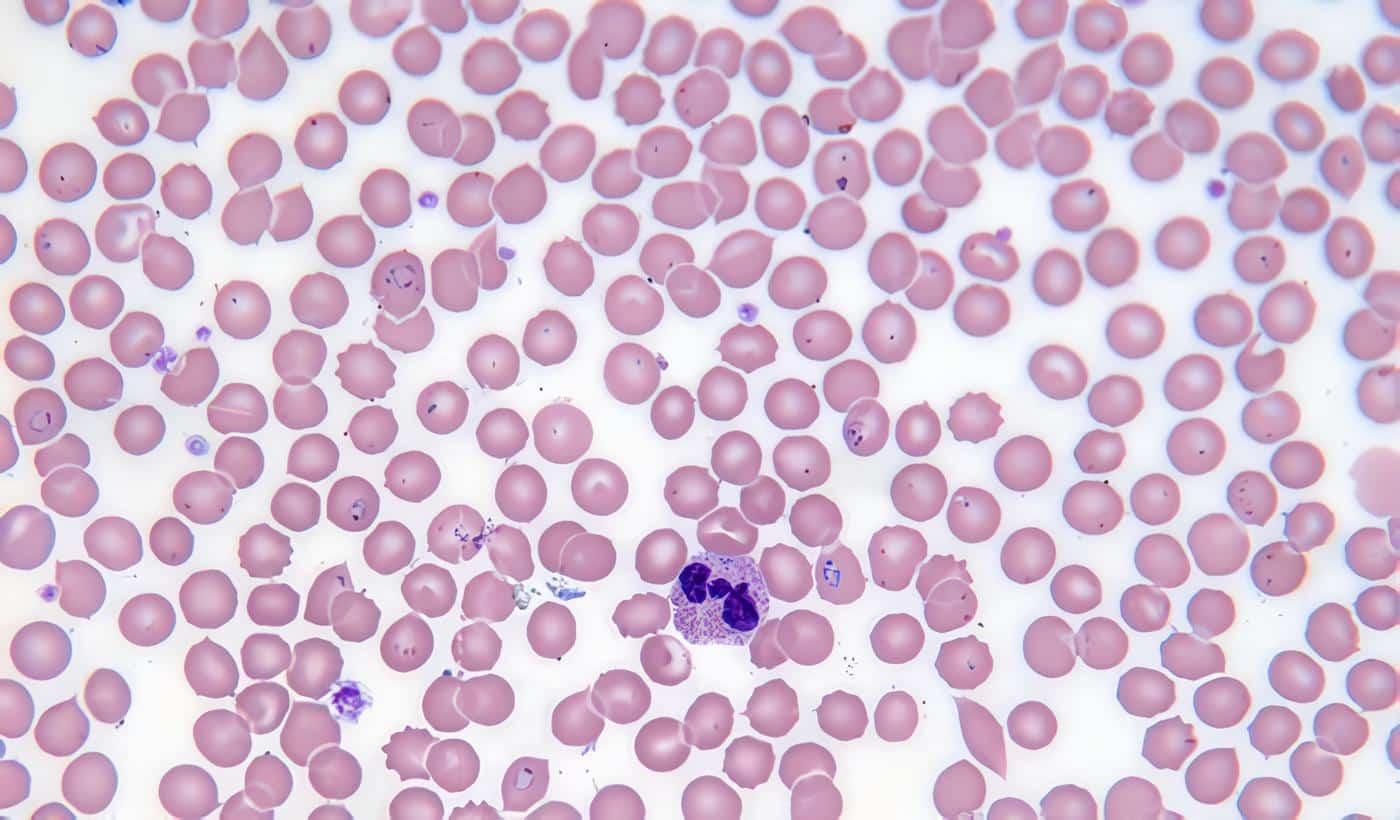

La vigilancia epidemiológica en el control de la malaria es una actividad indisociable de las acciones de atención al enfermo relativas al diagnostico temprano, tratamiento eficaz y oportuno y el seguimiento del paciente.
Todas las actividades de prevención y control de malaria ejecutadas por las distintas instituciones del Sistema general de seguridad social en salud deben ser registradas por los órganos ejecutores y notificadas a las entidades territoriales, departamentales, distritales y municipales correspondientes.
El ente encargado de la vigilancia epidemiológica de esta enfermedad en el país es el Instituto Nacional de Salud; del protocolo de vigilancia se tomo la siguiente definición:
“Paciente con escalofríos, episodio febril actual o reciente (> 37.5°C) acompañado de sudoración, procedente de área endémica de malaria por lo menos en los últimos quince días, confirmado mediante examen parasitológico.” (Lea también: Malaria Grave en el Embarazo)
Cuadro Resumen de Evidencia